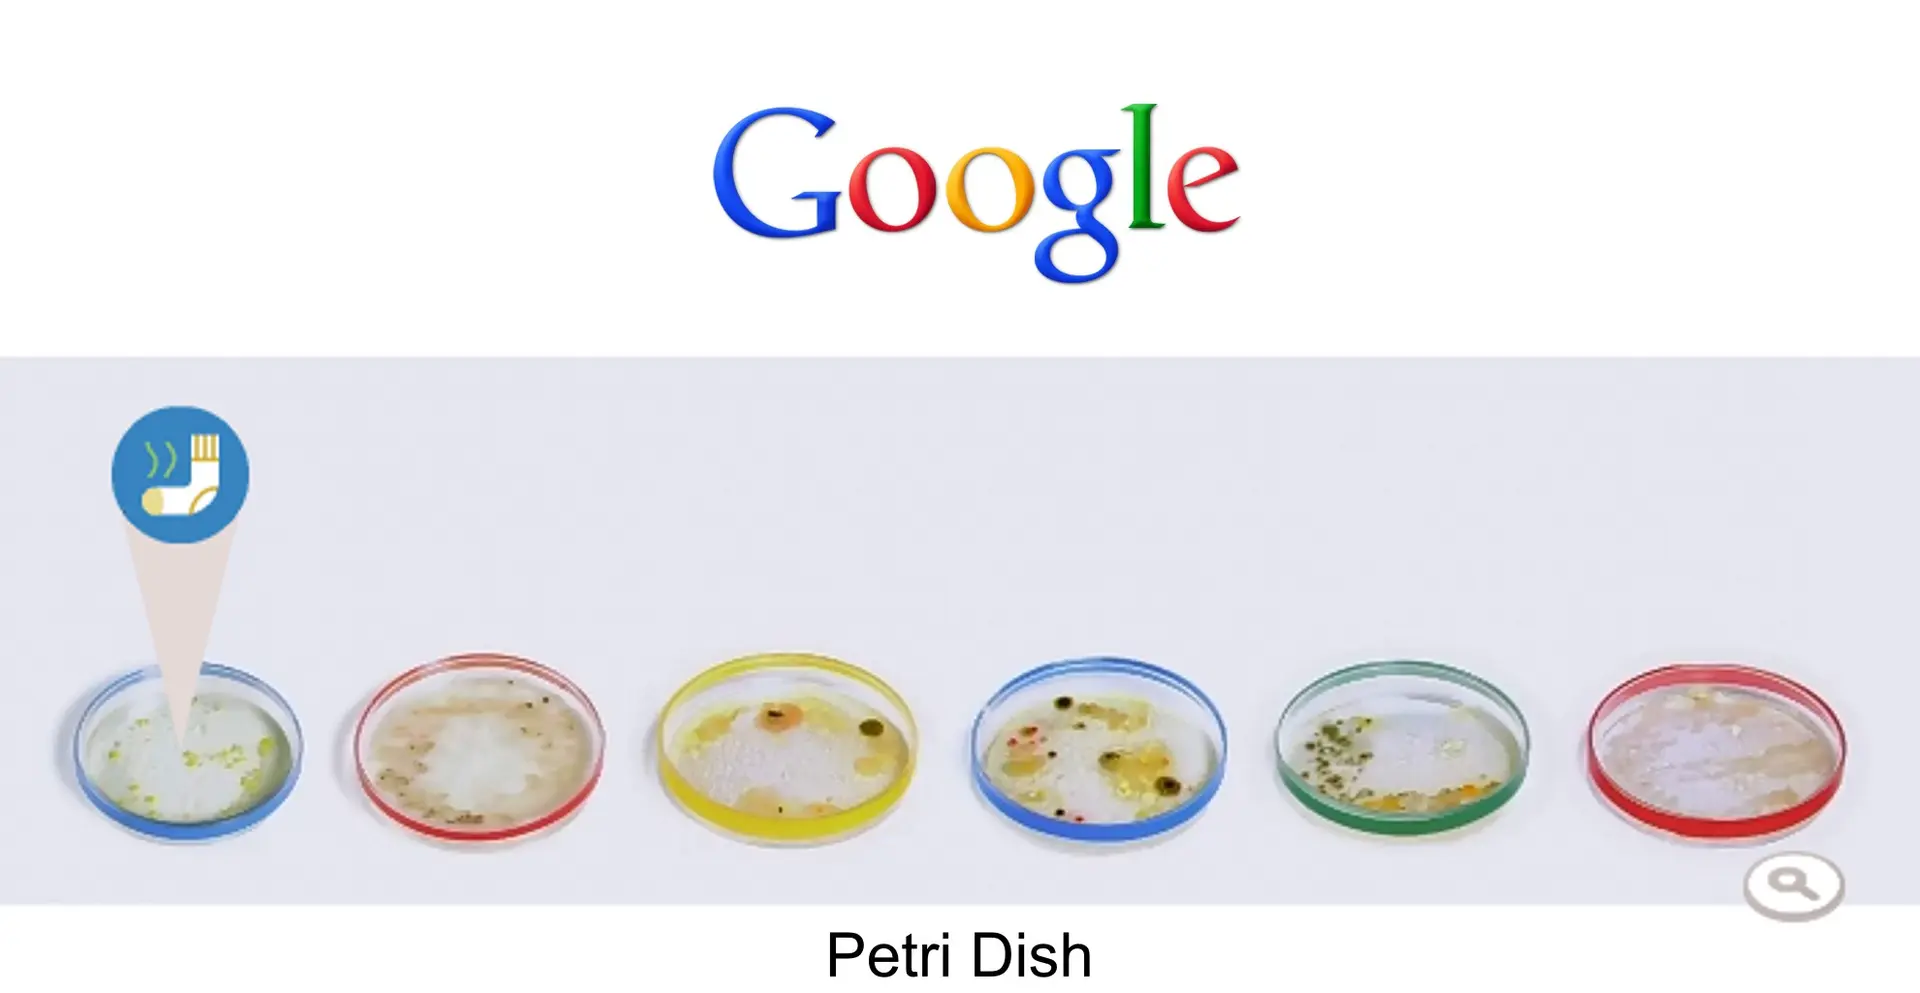
Petri Dish Google Doodle

Today Google is celebrating the life and legacy of Julius Richard Petri the inventor of the “Petri Dish”.

I first though that the Google Doodle have something to do with the inventor of DNA testing, but soon learned that Julius Richard Petri created the “Petri Dish” and not directly involved with DNA testing as we know it today.
What is the Julius Richard Petri Dish?
The Petri dish is a common piece of microbiology laboratory equipment which made of glass or transparent plastic. These are the main parts of today’s Google Doodle and there are six of them with different culturing cells brewing. By clicking the play button someone presumably Julius Richard Petri swaps and place different cultures into the “Petri Dish”
- The first Petri Dish contains what looks like a bacteria from a stinking sock.
- The Second a swap from a door, showing that doors are not as clean as many people think.
- The third Swap shows a sample taken from a keyboard and just looking at the bacteria and fungus growing from the keyboard I can tell that a Keyboard must be ranking tops among the dirtiest office equipment.
- The fourth swap shows bacteria taken from a dog, and whatever is growing in the dog swap does not look to good!
- The fifth Petri Dish shows a sample taken from a plant and it looks like it were raining when the swap was taken.
- The sixth swap shows a dish being washed, showing that cleaning does not kill 100% of bacteria.
The Google Doodle of Julius Richard Petri prompted me to find out what the Top 10 dirtiest places is in the home.
Top 10 dirtiest places at home
If you thought that your bathroom was the dirtiest place in your home, think again. In a 2011 germ study conducted by NSF International, 22 families swabbed 30 items in their homes. NSF’s microbiologists analyzed the results, looking to see where the highest levels of coliform bacteria, yeast, mold and/or Staph bacteria were present.
- Kitchen Sponge/Dish Rag: The item most frequently used to clean dishes and countertops was actually the dirtiest place found in most homes. Sponges and dish rags can pick up bacteria during the cleaning process, and, if not properly sanitized between uses, they can be a prime spot for germ growth.
- Kitchen Sink: The second highest concentration of microorganisms was found in the kitchen sink.
- Toothbrush Holder: The third dirtiest place in homes wasn’t actually in the kitchen, but the bathroom. And while many people would suspect faucet handles or light switches to be a germy place, the toothbrush holders in our test homes revealed more germs.
- Pet Bowl: If you have a pet in your home, you probably need to know that pet dishes were found to be the fourth dirtiest place in the homes analyzed.
- Coffee Reservoir: Rounding out the top five germiest places in the home was the coffee reservoir. Given the dark, damp location, it’s a prime location for bacteria, mold and mildew to grow.
- Faucet Handles: Faucet handles in both the kitchen and bath contained coliform bacteria as well as yeast and/or mold.
- Pet Toys: Pet toys were a source of coliform bacteria, yeast and mold in many homes, including Staph bacteria. Encourage your family to wash their hands after playing with the pet.
- Countertops: Countertops had coliform bacteria present in 30% of the homes tested. Sources of coliform can be traced to many food items, including unwashed produce as well as raw meat and poultry. Coliform can also be introduced into a kitchen area through improperly washed hands and through contact with household pets, including pet dishes and toys.
- Stove Knobs: While not a place that many of us think about, stove knobs are in the top ten for common places for germs to hide in our homes.
- Cutting Boards:. Because cutting boards may come into contact with many different foods, it’s important to make sure to thoroughly wash them after each use and between food types.
After looking at the top 10 dirtiest places and looking at today’s Julius Richard Petri Google Doodle it is clear that Google have done their homework when they chose the things to swap in today’s Google Doodle.
Many germs can be killed by washing your hands regularly, Proper hand washing includes scrubbing hands under warm water with soap for 20 seconds before rinsing and drying with a clean towel. I believe that this is part of the message that Google wants to give us today with celebrating the life and legacy of Julius Richard Petri.
Who Was Julius Petri (Wikipedia)
According to Wikipedia Julius Richard Petri (May 31, 1853 – December 20, 1921) was a German bacteriologist who is generally credited with inventing the Petri dish while working as assistant to Robert Koch.
Petri first studied medicine at the Kaiser-Wilhelm-Academy for Military Physicians (1871–1875) and received his medical degree in 1876. He continued his studies at the Charité Hospital in Berlin and was on active duty as a military physician until 1882, continuing as a reservist.
From 1877 to 1879 he was assigned to the Imperial Health Office (German: Kaiserliches Gesundheitsamt) in Berlin, where he became an assistant to Robert Koch. On the advice of Angelina Hesse, the New York-born wife of another assistant, Walther Hesse, the Koch laboratory began to culture bacteria on agar plates. Petri then invented the standard culture dish, or Petri plate, and further developed the technique of agar culture to purify or clone bacterial colonies derived from single cells. This advance made it possible to rigorously identify the bacteria responsible for diseases.















